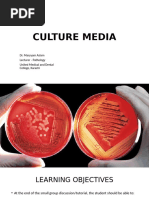
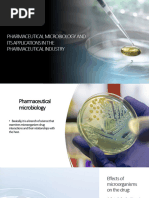

0% found this document useful (0 votes)
152 views2 pagesThayer Martin Medium Base: Composition
This document provides information about Thayer Martin Medium Base, which is used for selective isolation of Gonococci from pathological specimens. It lists the composition of the medium and provides directions for preparation and use. It also describes the principles, interpretation, quality control, cultural response and storage requirements.
Uploaded by
Abid SiddiquiCopyright
© © All Rights Reserved
We take content rights seriously. If you suspect this is your content, claim it here.
Available Formats
Download as PDF, TXT or read online on Scribd
0% found this document useful (0 votes)
152 views2 pagesThayer Martin Medium Base: Composition
This document provides information about Thayer Martin Medium Base, which is used for selective isolation of Gonococci from pathological specimens. It lists the composition of the medium and provides directions for preparation and use. It also describes the principles, interpretation, quality control, cultural response and storage requirements.
Uploaded by
Abid SiddiquiCopyright
© © All Rights Reserved
We take content rights seriously. If you suspect this is your content, claim it here.
Available Formats
Download as PDF, TXT or read online on Scribd
/ 2